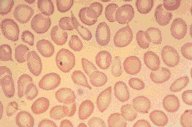

Description
This low oil magnification view of the peripheral blood shows moderate
variation in size and shape of the red cells as well as some variation
in their degree of hemoglobinization. Several teardrop cells are seen
in this field.
|
|
Click on this image
to enlarge it, then
on Back buttom
in the Netscape Menu
to shrink it back down



|